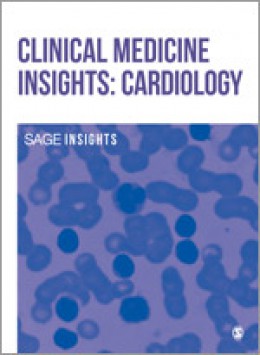

《Journal Of Primary Health Care》雜志目前處于幾區?
來源:優發表網整理 2024-09-18 11:30:38 175人看過
經過系統查詢,目前未查詢到中科院分區相關數據,可能是查詢條件不準確或數據暫未更新,建議咨詢雜志社或咨詢在線客服
中科院分區決定了SCI期刊在學術界的地位和影響力,對科研人員和學術機構具有重要的參考價值,具體如下:
對SCI期刊的評價:中科院分區通過將SCI期刊按照3年平均影響因子劃分為不同的等級,為科研人員和學術機構提供了一個評估SCI期刊學術影響力的重要依據。分區越高,說明該期刊在學科內的學術影響力越大,發表的文章質量越高。
對科研人員的成果評估:科研人員發表的論文所在的中科院分區,可以作為評估其研究成果質量的一個指標。
對科研資源的分配:中科院分區在科研資源分配方面也起到重要作用。科研機構在制定科研政策、分配科研資源時,會參考中科院分區。
對科研人員投稿的指導:中科院分區為科研人員選擇投稿期刊提供了參考。科研人員在選擇投稿期刊時,會參考中科院分區,以提高論文被接受的可能性,并增加研究成果的影響力。
《Journal Of Primary Health Care》雜志是一本國際期刊,由CSIRO Publishing?出版,
《初級衛生保健雜志》是一本專注于初級衛生保健領域的國際同行評審期刊。該期刊發表的內容通常涉及初級保健的臨床實踐、政策、教育、研究和管理等方面。它旨在為醫療保健提供者、研究人員、政策制定者和學生提供一個論壇,以便分享和討論有關提高全球初級衛生保健水平的研究和經驗。
期刊的特點包括強調跨學科研究、實踐導向的研究以及對全球健康挑戰的探討。通過發表原創研究、綜述、臨床試驗報告和觀點文章,雜志促進了初級衛生保健領域的知識傳播和專業發展。
《Journal Of Primary Health Care》雜志學術影響力具體如下:
在學術影響力方面,IF影響因子為1.1,顯示出其在學領域的學術影響力和認可度。
JCR分區:Q4
按JIF指標學科分區,在學科:PRIMARY HEALTH CARE中為Q4,排名:27 / 30,百分位:11.7%;
按JCI指標學科分區,在學科:PRIMARY HEALTH CARE中為Q3,排名:18 / 30,百分位:41.67%;
《Journal Of Primary Health Care》雜志的審稿周期預計為:平均審稿速度 28 Weeks ,投稿需滿足English撰寫,期刊注重原創性與學術嚴謹性,明確拒絕抄襲或一稿多投,Gold OA占比:100.00%,這使得更多的研究人員能夠免費獲取和引用這些高質量的研究成果。
該雜志其他關鍵數據:
CiteScore分區(數據版本:2024年最新版):2.7,進一步證明了其學術貢獻和影響力。
年發文量:52篇
CiteScore分區(數據版本:2024年最新版)
| CiteScore | SJR | SNIP | CiteScore排名 | ||||||||
| 2.7 | 0.325 | 0.439 |
|
名詞解釋:
CiteScore:衡量期刊所發表文獻的平均受引用次數。
SJR:SCImago 期刊等級衡量經過加權后的期刊受引用次數。引用次數的加權值由施引期刊的學科領域和聲望 (SJR) 決定。
SNIP:每篇文章中來源出版物的標準化影響將實際受引用情況對照期刊所屬學科領域中預期的受引用情況進行衡量。
聲明:以上內容來源于互聯網公開資料,如有不準確之處,請聯系我們進行修改。